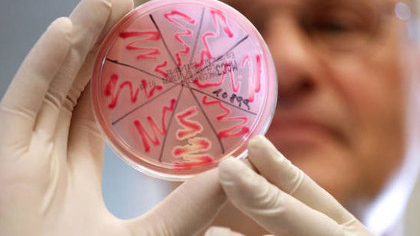
Інформує Лубенський підрозділ ДУ "«Полтавський обласний центр контролю та профілактики хвороб"

27 серпня біля кінотеатру «Київська Русь» відбулася благодійна акція «Школярик». Відділом сім’ї, молоді та спорту виконавчого комітету Лубенської міської ради (начальник Світлана Скиба) та Службою у справах дітей (начальник Тетяна Башлій) було роздано понад 200 шкільних наборів. Їх отримали першокласники із числа багатодітних сімей, діти учасників бойових дій та ВПО Лубенської громади, діти-сироти, діти, позбавлені батьківського піклування та діти з сімей, що перебувають у складних життєвих обставинах.
24 серпня у селі Снітин Лубенської територіальної громади відбувся щорічний традиційний турнір з міні-футболу, присвячений пам’яті уродженця села Снітин, фінансиста, Героя України Вадима Гетьмана.
У громаді свято шанують пам’ять українського банкіра, політика, відомого своїм вагомим внеском у становленні банківської системи України, впровадженні національної валюти України – гривні, а традиційний турнір – це вияв шани і поваги, пам’яті до нашого земляка. У відкритті спортивного заходу взяли участь перший заступник Лубенського міського голови Олег Соболєв, староста Литвяківського старостинського округу Валерій Ночовний, завідувач сектору з питань фізичної культури і спорту виконавчого комітету Лубенської міської ради Едуард Хромов. Вони побажали спортсменам вдалої гри, а найспритнішим – перемоги!
Вони народилися у вільній та незалежній державі, що нині відзначає своє 33-ліття. А ще мають одну мрію на всіх – мирне небо над головою. Саме на День Незалежності у Публічній бібліотеці імені Володимира Малика відбувся цікавий патріотичний брейн-ринг «В історію свою візьми нас, Україно!». Бібліотекар Лариса Гончарук запросила юних читачів помандрувати в минуле нашого народу, ознайомивши з основними віхами незалежної держави. Вікторину про національні та народні символи України провела для дітей бібліотекар Марина Кононенко. А потім учасники двох команд: «Козаки» та «Україночки» змагалися у різних турнірних завданнях.
Починаючи з 24 серпня українські виробники можуть подавати заявки на участь в програмі «Національний кешбек» через портал Дія. Про це повідомило Міністерство економіки України.
Відповідно до умов, програми кешбек надаватиметься на будь-які споживчі товари українського виробництва за виключенням підакцизних товарів. Зокрема, й на ліки українського виробництва. Участь виробників в програмі добровільна, отже кешбек надаватиметься не на всі товари, а на ті, які будуть подані виробником для участі в програмі.
24 серпня, у День Незалежності України, біля пам’ятного знаку «Україна незалежна», що у Центральному парку культури і відпочинку, відбулася патріотична акція «Сильні. Вільні. Незалежні». Участь у патріотичному заході взяли представники влади, адміністрація та студенти Луганського національного університету імені Тараса Шевченка, громадськість, активні лубенці.
З нагоди державного свята пролунав гімн України. Хвилиною мовчання вшанували пам’ять загиблих українців. Свобода й незалежність для українців завжди були пріоритетом. Століттями наш народ виборював право жити вільно, бути господарями на своїй землі. Прагнення волі, демократії, незалежності об’єднували цілі покоління, кликали на боротьбу упродовж століть. Сьогодні українці боронять рідну землю, відстоюють незалежність, як і наші пращури. І хоч нашій державі лише 33 роки, її боротьба, слава і звитяга сягає корінням у далеке минуле, яке свято шанують нащадки, нищать ворога, що посягнув на незалежність мирної країни, - про це у вітальних виступах говорили Лубенський міський голова Олександр Грицаєнко та ректор Луганського національного університету імені Тараса Шевченка Олена Караман. Вони побажали українцям миру, а Україні - якнайшвидшої перемоги!
У зв’язку із проведенням робіт у мережах АТ «ПОЛТАВАОБЛЕНЕРГО» можливі тимчасові перерви в електропостачанні споживачів. Дата, орієнтовний час початку та закінчення перерви вказані у таблиці.
Слава Україні! Розпочалась 917-та доба широкомасштабної збройної агресії російської федерації проти України. Загалом від початку цієї доби відбулося 125 бойових зіткнень. Українські захисники продовжують рішуче давати відсіч спробам противника просунутися в глибину нашої території, завдаючи йому вогневого ураження. Найгарячіша ситуація залишається на Покровському напрямку.
Російські загарбники завдали по території України два удари, випустивши дев’ять ракет, та 64 авіаудари, скинувши 72 КАБи. Крім цього, залучили для ураження 558 дронів-камікадзе та здійснили понад 2800 обстрілів по позиціях наших військ і населених пунктах. На Харківському напрямку точилося вісім боїв. Сили оборони відбивали наступ росіян неподалік Вовчанська. Ворожа атака досі продовжується. На Куп’янському напрямку впродовж дня відбулося 16 боєзіткнень. Ворог атакував біля Синьківки, Новоселівки, Колісниківки та Стельмахівки. Наразі тривають чотири атаки противника. На Лиманському напрямку російські загарбники здійснили штурмові дії поблизу Дружелюбівки, Невського та Новосадового. Сім боїв завершено, два – продовжуються.
На Сіверському напрямку оборонці української землі відбили ворожий наступ у районі Верхньокам’янського. На Краматорському напрямку точилося 12 боїв неподалік Григорівки, Іванівського, Андріївки та Кліщіївки. На цей момент триває одна штурмова дія противника. Ситуація під контролем наших військ. Українські захисники продовжують рішуче давати відсіч спробам противника просунутися в глибину нашої території, завдають йому ефективного вогневого ураження, виснажуючи по всій лінії фронту.
23 серпня у Центрі культури і дозвілля відбувся патріотичний захід «Нація сильних», присвячений одному з найважливіших державних свят – Дню Незалежності України. У святковому концерті взяли участь представники влади, працівники органів місцевого самоврядування, військовослужбовці, волонтери, громадськість.
Нашій державі виповнилося 33 роки. Шлях її ставлення тернистий, сповнений випробувань, сліз радощів, гірких втрат і віри в перемогу. Концерт розпочався відеороликом про становлення нації, про боротьбу за незалежність, яка сьогодні відстоюється ціною життя синів і доньок України.
Минулого тижня Україна відзначала два найбільші державні свята – День Державного Прапора та День Незалежності України. У Центрі культури і дозвілля та його філіях відбувся ряд заходів на їх відзначення.
На благодійних концертах у філіях Войнихівський, Ісковецький, Вищебулатецький, Хорошківський, Калайдинцівський, Новаківський, Михнівський, Мацківський, Оріхівський, Засульський, Окіпський, Шершнівський Снітинський СБК та у Центрі культури і дозвілля збирали кошти та смаколики для наших захисників. В окремих закладах були також організовані благодійні виставки та ярмарки.
Лубенський районний відокремлений підрозділ Державної установи «Полтавський обласний центр контролю та профілактики хвороб Міністерства охорони здоров'я України» інформує про ситуацію щодо інфекційнійної захворюваності за 34 тиждень на території Лубенської територіальної громади.
У зв’язку із проведенням робіт у мережах АТ «ПОЛТАВАОБЛЕНЕРГО» можливі тимчасові перерви в електропостачанні споживачів. Дата, орієнтовний час початку та закінчення перерви вказані у таблиці